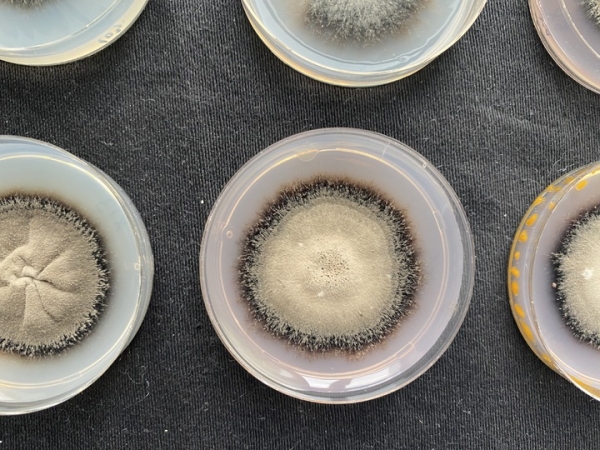
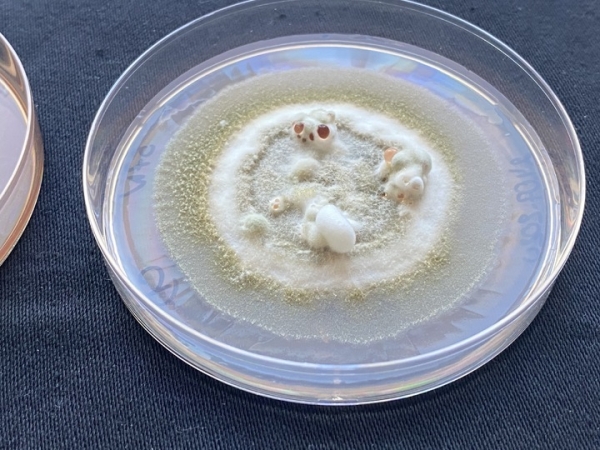
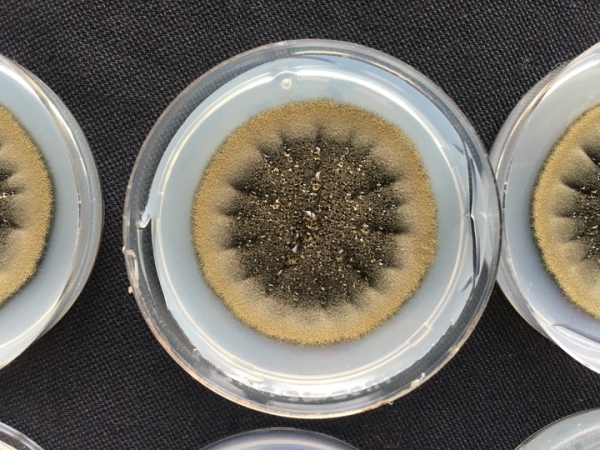

Микромир Третьяковки: на иконах нашли организмы, подходящие для создания лекарств
Микробиологи, обследовавшие музей, совершили удивительное открытие
Высокое искусство может лечить не только душу, но и тело. Специалисты федерального исследовательского центра «Фундаментальные основы биотехнологии» РАН, которые недавно завершили работу по определению микробиома Государственной Третьяковской галереи, совершили открытие: плесень, обнаруженная в залах древнерусской живописи, в ходе профилактических работ, может быть использована для создания лекарств-стероидов. Руководитель группы генетической инженерии грибов, кандидат биологических наук Александр Жгун рассказал «МК» о находке и о самом проведенном исследовании.

Aspergillus versicolor STG-25G. Фото: Александр Жгун.
Кто живет в музее
— Александр Александрович, чем была вызвана необходимость микробиологического обследования в музее?
— Во всех ведущих музеях мира за состоянием объектов культурного наследия строго следят реставраторы в сотрудничестве с учеными. Существует масса научных статей о микробиологическом состоянии ведущих хранилищ культурных ценностей, таких как Лувр, Уффици, или Британский музей.
В России за состоянием учреждений, где хранятся и экспонируются памятники истории и культуры, также зорко следят хранители, реставраторы и специальные службы. К примеру, существуют службы, которые периодически делают заборы воздуха в залах для определения предельного микробиологического фона. Если определяют, что он превышен – приглашают более узких специалистов, то есть нас, чтобы мы более тонко изучили активизировавшееся микробное сообщество, или микробиом.
— Слышала про такой в человеческом кишечнике…
— Свой микробиом есть везде. Есть такое понятие, как больничная инфекция. Пациент с переломом ноги поступает в больницу и подхватывает там стафилококк, который может вызывать респираторные и другие заболевания. Откуда он взялся? Из больничного микробиома. Несмотря на то, что в медицинских учреждениях периодически проводят тщательную дезинфекцию, раз в несколько лет он дает о себе знать, «вылезая» из каких-то резервуаров, узких трещин в стенах.
Или, другой пример: нью-йоркское метро. Его микробиом может «проснуться», когда разливается Гудзон, и в подземке резко повышается влажность. Нечто подобное может происходить и в музеях: микробиота может таиться здесь на поверхностях стен, картин, рам.
Как все начиналось
— С чего началась ваша работа в Третьяковской галерее?
— Идея привлечь к исследованию микробиологического сообщества наш коллектив родилась в 2018 году. Для нас, больше занимающихся фундаментальной наукой, это был первый опыт такого практического взаимодействия с музейщиками. Нам дали для изучения проблемную зону, которая по результатам нескольких мониторингов показывала превышение микробиологического фона в несколько раз. Речь шла о зале №61 древнерусской живописи, основного исторического здания Третьяковской галереи (Москва, Лаврушенский переулок 10).

Cladosporium parahalotolerans STG-93B. Фото: Александр Жгун.
Важнейшими объектами культурного наследия в нем считаются икона «Благословенно воинство Небесного Царя» (1550-е годы), и фрагмент скульптуры «Святой Великомученик Георгий Победоносец» (1464 года). Там же находилась икона «Святой Великомученик Димитрий Солунский» (XVI века).
– Вы обнаружили на них бактерии и грибы?
— Визуальный осмотр этого не установил, – за иконами и каменным бюстом, покрытым темперой, очень хорошо следили реставраторы. Но поскольку микробиологический фон в зале был превышен, мы отобрали с этих экспонатов микробиологические пробы для анализа.
— Как это делается?
– Сухой ватной палочкой, которую затем помещают в специальную пробирку, Эппендорф, с «реанимационной» для микроорганизмов жидкой средой. После того, как иконы перенесли в другое помещение, выяснилось, что за демонстрационными щитами в кабель-каналах, в трещинах потолка находятся видимые глазом очаги развития микроорганизмов. Во всех этих зонах также отобрали пробы. Мы также отобрали пробы в соседних залах древнерусской живописи.

Aspergillus versicolor STG-86. Фото: Александр Жгун.
Из проб, отобранных с экспонатов и поверхностей залов, выделили так называемые экологические ДНК, по которым определили соответствующие составы микробиомов. Всего в залах древнерусской живописи Третьяковской галереи мы определили примерно 700 различных бактерий и около 300 различных грибов.
— Откуда они там взялись? В зале наверняка должен был соблюдаться особый режим температуры и влажности.
— Он, конечно, соблюдался! В музее круглосуточно поддерживается этот баланс: 19оС и 55% влажности, при которых не происходит развития микроорганизмов. Проблема, как выяснилось, была связана с той самой стеной, на которой обнаружили рост микроорганизмов. Она выходит на Лаврушинский переулок. Если зимой на улице -20оС, а в зале +19оС, то в какой-то зоне стены температура будет 0оС, что соответствует так называемой «точке росы». В этой зоне появляется влага, и могут развиваться микроорганизмы.
Microascus paisii STG-103. Фото: Александр Жгун.
Оказалось, что эта точка росы находилась в стене близко от экспонатов. В идеале, чтобы избежать этого, можно сместить точку росы за пределы здания, сделав наружный сайдинг. Однако само здание Третьяковской галереи является объектом культурного наследия, а потому делать этого не разрешается.
Особенный микробиом
— Каковы были дальнейшие действия?
— Проблемную стену и весь 61-й зал обработали, в том числе в соответствии с нашими рекомендациями. Несколько лет он находился без экспонатов, на так называемой выдержке. И только когда окончательно убедились, что больше плесень там не образуется, вернули все экспонаты обратно. Это произошло в прошлом году.

Взятие пробы с иконы «Бгагословенно воинство Небесного царя»
Однако до конца успокаиваться нельзя. На иконах и фрагменте скульптуры «Святой Великомученик Георгий Победоносец» могут находиться споры микроорганизмов. Это подтвердили и микробиологические пробы, взятые с экспонатов и залов живописи древнерусского искусства. Те самые микроорганизмы, которые были в раскрытых очагах на стене, присутствовали в следовом количестве на самих художественных произведениях.

Cladosporium halotolerans STG-52B + Xn. Фото: Александр Жгун.
— Так в чем же оказалась особенность микробиома залов древнерусской живописи?
— Он особенный. Он формировался в течение многих десятилетий, под воздействием двух процессов – консервации и реставрации, направленных на сохранение объектов культурного наследия, в том числе, от микробиологического поражения. Но это не убивает все вредные микроорганизмы, а производит их жесткую селекцию.

Макет с особенностями древнерусской живописи с развившейся плесенью
Подвергаясь прессингу реставрации и консервации, в стенах музея выживают только очень сильные. Прежде всего, это ксерофильные микроорганизмы, которые устойчивы к повышенной сухости. Если большинство умирает при влажности 85% и ниже, то ксерофилы адаптированы для существования при влажности до 65-62%.
Aspergillus creber STG-57. Фото: Александр Жгун.
В условиях музейного хранения влажность — 55%, однако, дыхание всего одного посетителя, проходящего рядом с экспонатом, дает дополнительную влажность, которой становится достаточно для развития микроорганизмов.
– Что с этими ксерофилами делать дальше?
— Обрабатывать икону, которая является национальным достоянием, формалином или концентрированным медным купоросом нельзя, – навредим, повредятся краски. Остается лишь одно – мониторить ее состояние. Например, сообщества микроорганизмов, выделенных с одной иконы, мы культивируем на стандартных питательных средах, а затем выделяем каждый вид в чистые линии и наносим их на макеты с технологическими особенностями древнерусской живописи (их изготовили в рамках совместной работе в отделе научной реставрации древнерусской живописи Третьяковской галереи под руководством Михаила Валерьевича Шитова).
— Проверяете, какие из них пойдут в рост?
— Да, точнее, – какие из них могут вызвать деструкцию материалов, использующихся в темперной живописи.

Penicillium chrysogenum STG-117. Фото: Александр Жгун.
— И какой итог?
— В итоге в микробиоме залов древнерусского искусства мы выявили потенциально опасные микроорганизмы, относящиеся к плесневым грибам. Аспергилл разноцветный и улоклада выделены c поверхности иконы «Благословенно воинство Небесного Царя» (1550-е годы). Кладоспора галотолерантная — выделена c поверхности фрагмента скульптуры «Святой Великомученик Георгий Победоносец» (1464 года).
Аспергилл Кребера выделен c поверхности иконы «Святой Великомученик Димитрий Солунский» (XVI в.). Кладоспора парагалотолеранс, Симплицилиум пластинчатый и различные аспергиллы — выделены с поверхностей зала № 61. Микроаск паисий — выделен из зала № 57. Аспергилл выступающий выделен из зала № 56. Пеницилл хризогенум — выделен с поверхности иконы «Пророк Соломон» (1731 г.).
— И как с ними бороться?
— Бороться с ними надо будет только в том случае, если микробиом начнет развиваться. Тогда объекты музейного хранения обрабатывают специальными антисептиками, используемыми при реставрации живописи.
Cladosporium halotolerans STG-52B. Фото: Александр Жгун.
В последнее время количество действующих препаратов сокращается, – у картин, как и у людей, вырабатывается к ним резистентность. К тому же надо быть очень осторожными с ними, поскольку некоторые классы «лекарств» способны повреждать пигмент.
Сейчас мы проверяем действие на наши макеты с грибами-деструкторами новых антисептиков, разрабатываемых в совместной работе ведущими российскими научными коллективами химиков-синтетиков. Многие из них обладают широким спектром действия, способны бороться с консорциумами грибов и бактерий.
Лекарство с иконы
– Из каких микроорганизмов, встреченных вами в Третьяковской галерее, можно делать лекарства?
— Оказалось, что все изолированные грибы-деструкторы живописных материалов способны трансформировать стероидные субстраты, что необходимо при промышленном получении конечных препаратов. Для примера, – при скрининге других перспективных групп, стероиды эффективно трансформировали не более 20-50% микроорганизмов, но не 100%.

Aspergillus protuberus STG-106. Фото: Александр Жгун.
Справка «МК». Стероиды – это лекарственные препараты, которые позволяют воздействовать на организм человека, например, менять гормональный статус в случае отклонений, снимать воспаления, боль (в суставах, мышцах, при болях, вызванных раздражением или защемлением нерва), а также лечить специфические состояния, в том числе: астму, сенную лихорадку, крапивницу, экзему, заболевания кишечника (например, болезнь Крона), волчанку, рассеянный склероз. В настоящее время применяется около 300 типов стероидных препаратов.

Икона «Бгагословенно воинство Небесного царя» с указанием мест, откуда ученые брали биопробы.
– За счет чего они стали такими?
– Все дело в темпере, – особых многокомпонентных красках, которыми писались древние иконы. В их основе яичный желток – самая богатая субстанция по количеству холестерина, что роднит ее со стероидами.
Нашей исследовательской группе пришла идея проверить грибы, питающиеся темперой (богатой холестерином), на способность взаимодействовать с фармпрепаратами стероидного класса. Наши эксперименты увенчались успехом – эти микроорганизмы действительно оказались способны трансформировать, модифицировать структуру препаратов. На этой основе фармакологам, возможно, удастся создать много новых видов более совершенных стероидов.

Александр Жгун возле музейной стены, которая выходит на Лаврушинский переулок
«Удивительное – рядом!» – гласит крылатая фраза. Не только фундаментальная наука, но и ее прикладная часть ведут порой к самым неожиданным и приятным «побочным эффектам». В поисках средств для уничтожения вредных организмов на предметах искусства, исследователи неожиданно открыли большую группу полезных модификаторов для фармакологии.

Александр Жгун в зале древнерусской живописи
Источник: www.mk.ru